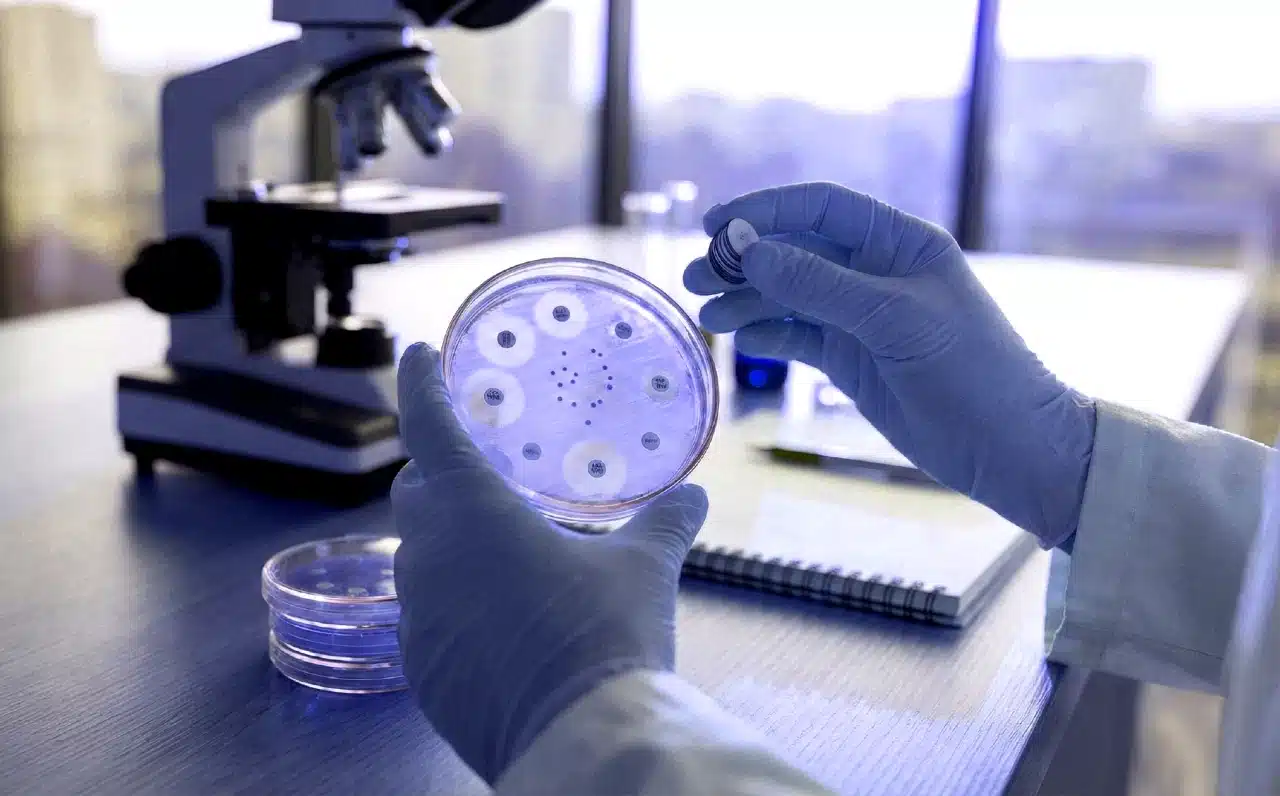
antibiyotik direnci gelişen bakterilerin mikroskobik görünümü

Antibiyotiklerin yanlış ve bilinçsiz kullanımı, modern tıbbın karşılaştığı en büyük küresel sağlık tehditlerinden biri haline geldi. Uzmanlar, özellikle antibiyotik direnci gelişiminin enfeksiyonlarla mücadeleyi zorlaştırdığını ve bu durumun “sessiz pandemi” olarak adlandırıldığını vurguluyor. Bilinçsiz ilaç tüketimi, bugün basit görünen hastalıkların gelecekte tedavi edilemez hale gelmesine yol açma riski taşıyor.
📌 Öne çıkanlar:
- Gereksiz antibiyotik kullanımı bakterilerin ilaçlara karşı bağışıklık kazanmasına ve dirençli suşların oluşmasına neden oluyor.
- Direnç gelişimi sonucunda tedavi süreçleri uzarken, hastanede yatış süreleri ve ölüm riski ciddi oranda artış gösteriyor.
- Antibiyotikler ateş düşürücü veya ağrı kesici değildir; her enfeksiyon türünde bu ilaçlara başvurulmaması gerekiyor.
- Hekimler dirençli vakalarda daha maliyetli ve yan etkisi daha fazla olan güçlü ilaçları kullanmak zorunda kalıyor.
🦠 Yanlış kullanımın bedeli: Antibiyotik direnci
Antibiyotiklerin yanlış ve gereksiz kullanımı, bu ilaçlara dirençli bakterilerin ortaya çıkmasına yol açarak enfeksiyonların tedavisini her geçen gün daha da zorlaştırıyor. Bu durum sadece bireysel sağlığı değil, toplum sağlığını da tehlikeye atarak hastalık sürelerinin uzamasına, hastanede yatışların artmasına ve ölüm riskinin yükselmesine neden olabiliyor. Anadolu Sağlık Merkezi Hastanesi’nden Enfeksiyon Hastalıkları Uzmanı Prof. Dr. Aytaç Çetinkaya, hekimlerin böyle dirençli tablolarla karşılaştığında çok daha güçlü, daha pahalı ve maalesef daha fazla yan etkiye sahip ilaçlara yönelmek zorunda kaldığını vurguladı.
🛡️ Antibiyotikler ağrı kesici veya ateş düşürücü değildir
Toplumda antibiyotik kullanımıyla ilgili doğru bilinen yanlışlara dikkat çeken Prof. Dr. Aytaç Çetinkaya, önemli uyarılarda bulundu. Çetinkaya, “Antibiyotikler ateş düşürücü ya da ağrı kesici değildir, bu nedenle her enfeksiyonda işe yaramaz. Gereksiz kullanımlar bugün fayda sağlamadığı gibi, yarın gelişen direnç nedeniyle daha ciddi bir hastalıkta kişinin tedavisiz kalmasına da yol açabilir” dedi. Özellikle viral enfeksiyonlarda antibiyotiklerin etkisiz olduğunun altını çizen uzmanlar, bu ilaçların yalnızca hekim önerisiyle ve belirtilen dozda kullanılması gerektiğini hatırlatıyor.
🧬 Antibiyotik direnci nedir ve nasıl gelişir?
Bakterilerin kendilerini yok etmek amacıyla tasarlanan ilaçlara karşı hayatta kalma mekanizmaları geliştirmesi durumuna antibiyotik direnci denir. Bu biyolojik bir savunma sürecidir; ancak insanların gereksiz yere veya eksik dozda ilaç kullanması bu süreci hızlandırır. Antibiyotiğe maruz kalan ancak tamamen ölmeyen bakteriler, ilacın etkisinden kurtulmak için genetik mutasyonlar geçirir. Bu dirençli bakteriler çoğalarak diğer insanlara yayıldığında, standart tedaviler işe yaramaz hale gelir. Sonuç olarak, tıp dünyasında “süper böcekler” olarak adlandırılan ve mevcut tüm ilaçlara direnç gösteren mikroorganizmalar ortaya çıkar.
“Antibiyotik direnci, sadece bireyin değil, tüm insanlığın gelecekteki sağlık güvenliğini tehdit eden küresel bir krizdir.”
🌍 Bilinçsiz ilaç kullanımının toplum sağlığı üzerindeki etkileri
Toplumda yaygın olan “her hastalığa antibiyotik” yaklaşımı, sağlık sistemleri üzerinde ağır bir yük oluşturmaktadır. Dirençli bakterilerin neden olduğu enfeksiyonlar, standart enfeksiyonlara göre çok daha zor tedavi edilir. Bu durumun toplumsal yansımaları şunlardır:
- Tedavi Maliyetlerinde Artış: Birinci basamak ilaçlar etkisiz kaldığında, çok daha pahalı ve genellikle sadece hastane ortamında damar yoluyla uygulanabilen ilaçlara ihtiyaç duyulur.
- Hastanede Yatış Sürelerinin Uzaması: Tedavisi zor enfeksiyonlar nedeniyle hastalar daha uzun süre gözetim altında tutulur, bu da hastane kaynaklarının tükenmesine yol açar.
- Artan Ölüm Oranları: Modern tıbbın en büyük başarıları olan organ nakilleri, kanser kemoterapileri ve cerrahi operasyonlar, enfeksiyon kontrolü sağlanamazsa büyük risk altına girer.
🚫 Hangi enfeksiyonlarda antibiyotik kullanımı etkisizdir?
Antibiyotikler yalnızca bakteriyel enfeksiyonlarla savaşmak için üretilmiştir. Toplumda sıkça görülen ve viral kaynaklı olan pek çok hastalıkta bu ilaçların hiçbir etkisi yoktur.
Özellikle aşağıdaki durumlarda antibiyotik kullanımı tamamen gereksizdir:
- Grip ve nezle gibi viral solunum yolu hastalıkları.
- Çoğu boğaz ağrısı (strep boğazı hariç).
- Bazı kulak enfeksiyonları ve sinüzit vakalarının büyük bir kısmı.
- Viral kaynaklı mide ve bağırsak enfeksiyonları.
Viral bir hastalıkta antibiyotik kullanmak, vücuttaki faydalı bakterilerin de ölmesine ve bağışıklık sisteminin dengesinin bozulmasına neden olur.
🛡️ Bireysel olarak antibiyotik direncini önlemek için neler yapılabilir?
Bu “sessiz pandemi” ile mücadelede her bireyin alabileceği basit ama kritik önlemler bulunmaktadır. Antibiyotik direncini kontrol altına almak için şu kurallara uyulmalıdır:
- Sadece Doktor Önerisiyle Kullanın: Komşunuzun tavsiyesiyle veya eski bir reçeteyle asla ilaç kullanmayın.
- Tedaviyi Yarım Bırakmayın: Kendinizi iyi hissetseniz bile doktorun belirttiği sürenin sonuna kadar ilaca devam edin. Erken bırakılan tedavi, hayatta kalan bakterilerin direnç kazanmasına neden olur.
- Doz Atlamayın: İlacı günün belirli saatlerinde ve düzenli olarak almak, kandaki ilaç seviyesini koruyarak bakterilerin boşluk bulmasını engeller.
- Hijyene Önem Verin: El yıkama gibi temel hijyen kuralları, enfeksiyonların yayılmasını önleyerek antibiyotik ihtiyacını en baştan azaltır.
❓ Sıkça sorulan sorular
- Antibiyotik direnci bir kez oluştuktan sonra geçer mi?
Direnç kazanan bir bakteri türü için o ilaç artık etkisizdir ancak dirençli bakterilerin toplumdaki yayılımı, akılcı ilaç kullanımı ve sıkı hijyen önlemleri ile zamanla azaltılabilir. - Soğuk algınlığında antibiyotik içmek iyileşme sürecini hızlandırır mı?
Hayır, soğuk algınlığı virüslerden kaynaklanır ve antibiyotikler virüslere karşı etkisiz olduğu için iyileşme sürecini hızlandırmaz, aksine yan etkilerle vücudu yorar. - Antibiyotik direncine sahip bir bakteri başkasına bulaşabilir mi?
Evet, dirençli bakteriler tıpkı diğer bakteriler gibi temas, hava yolu veya ortak kullanım alanları aracılığıyla insandan insana kolayca bulaşabilir. - Ateş yükseldiğinde hemen antibiyotik kullanılmalı mıdır?
Hayır, ateş birçok farklı hastalığın belirtisidir ve her ateş bakteriyel bir enfeksiyona işaret etmez; doğru teşhis için mutlaka bir hekime danışılmalıdır. - Antibiyotik kullanımı neden bağırsak sistemini bozar?
Antibiyotikler vücuttaki zararlı bakterileri hedeflerken, sindirim sisteminde bulunan ve bağışıklık için kritik olan dost bakterilere de zarar vererek dengeyi bozabilir.
🌐 Bunlar da ilginizi çekebilir:
- Antibiyotiklerin Altın Çağı Sona Eriyor
Antibiyotik direnci, ilaç geliştirme süreçleri ve küresel sağlık etkileri hakkında kapsam, güncel riskler ve istatistikler. - Antibiyotik Kullanırken Yiyecekler
Antibiyotiklerle etkileşime giren besinler, emilim ve yan etki profilleri, günlük beslenmede dikkat edilmesi gereken başlıklar. - Dünya Sağlık Örgütü: Acil Olarak Yeni Antibiyotikler Gerekiyor
Küresel antibiyotik direnci tehdidi, araştırma-geliştirme ihtiyacı ve sağlık politikalarına ilişkin uyarılar.
🔗 Kaynaklar:
- Antimicrobial Resistance Benchmark 2026. The Access to Medicine Foundation. (Retrieved: 9 February 2026).
- Draft updated global action plan on antimicrobial resistance. World Health Organization. Executive Board 158th session Provisional agenda item 14 EB158/18. (8 January 2026).